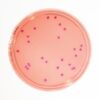

| Tên sản phẩm: | Rappaport Vassil.-B. acc. EP Merck |
| Code: | 1461810020 |
| Hãng- Xuất xứ: | Merck – Đức |
| Ứng dụng: | – Là hóa chất dùng để làm giàu chọn lọc Salmonella spp trong nuôi cấy vi sinh vật |
| Tính chất: |
– Hình thể: Ống thử nghiệm môi trường cấy đã sẵn sàng sử dụng màu xanh dương sạch. – Độ pH: 5,2 – Sản phẩm ổn định về mặt hóa học trong điều kiện môi trường chuẩn (nhiệt độ phòng) |
| Bảo quản: | Ở nhiệt độ từ +2°C đến +25°C. |
| Quy cách: | 20 ống/ hộp |
Sản phẩm tham khảo:
| Code | Quy cách |
| 1461810020 | 20 ống/ hộp |
| 1461810100 | 100 ống/ hộp |

Đánh giá
Chưa có đánh giá nào.